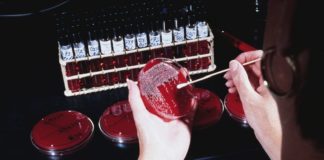
Infezioni correlate all’assistenza e antimicrobicoresistenza

Tag: infezioni
Studio delle Università di Napoli, Milano e Palermo
Latte fermentato con Lactobacillus paracasei CBA L74 per infezioni e allergie...
Uno studio multicentrico su latte fermentato con Lactobacillus Paracasei CBA L74 ne conferma l'efficacia nel ridurre infezioni e allergie infantili
Latte fermentato
Latte formulato per stimolare il sistema immunitario
L'ingrediente funzionale "Latte Fermentato con Lactobacillus Paracasei CBA L74" esplica un’attività postbiotica, modulando il sistema immunitario in età prescolare
Le linee guida sul risk management della Regione Lazio
Buone pratiche cliniche per prevenire le infezioni nosocomiali
Adottare adeguati processi significa gestire meno complicanze e cronicità future
Pubblicazione AIIPA